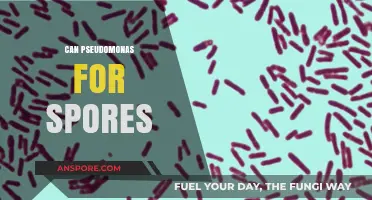
Can Pseudomonas Form Spores? Unraveling the Bacterial Survival Mystery

Pulsed xenon, a novel disinfection technology, has garnered significant attention for its potential to combat Clostridioides difficile (C. diff) spores, which are notoriously resistant to traditional cleaning methods. Utilizing intense, broad-spectrum ultraviolet (UV) light, pulsed xenon systems emit high-energy pulses that target the DNA of microorganisms, disrupting their ability to replicate and survive. Given the rising prevalence of C. diff infections in healthcare settings, which are often linked to spore persistence on surfaces, researchers and healthcare professionals are exploring whether pulsed xenon can effectively inactivate these resilient spores. Early studies suggest that pulsed xenon may offer a promising solution, providing rapid and thorough disinfection without the use of chemicals, thereby reducing the risk of healthcare-associated infections and improving patient safety. However, further research is needed to fully understand its efficacy, optimal application methods, and long-term impact on C. diff spore eradication.
| Characteristics | Values |
|---|---|
| Effectiveness Against C. diff Spores | Pulsed xenon ultraviolet (PX-UV) light is effective in reducing Clostridioides difficile (C. diff) spores on surfaces. Studies show significant log reductions in spore counts. |
| Mechanism of Action | PX-UV emits broad-spectrum UV light, including UV-C, which damages DNA and RNA, preventing spore germination and replication. |
| Efficacy Rate | Achieves up to 4-5 log reductions in C. diff spores within a single cycle, depending on exposure time and distance. |
| Exposure Time | Typically requires 5-10 minutes of exposure for effective spore inactivation. |
| Safety | Safe for use in healthcare settings when operated according to guidelines, as it does not produce ozone or mercury. |
| Surface Compatibility | Effective on a variety of surfaces, including stainless steel, plastic, and fabric, without causing damage. |
| Application in Healthcare | Widely used in hospitals for terminal room disinfection to prevent healthcare-associated infections (HAIs). |
| Comparison to Other Methods | More efficient than traditional UV systems and chemical disinfectants in reducing C. diff spores. |
| Limitations | Effectiveness depends on line-of-sight; shadows or obstructed areas may reduce efficacy. |
| Regulatory Approval | Approved by regulatory bodies such as the FDA for use in healthcare disinfection. |
| Cost | Higher initial investment compared to chemical disinfectants but lower long-term operational costs. |
| Environmental Impact | Environmentally friendly, as it does not produce harmful byproducts or require chemical disposal. |
Explore related products
What You'll Learn

Effectiveness of Pulsed Xenon on C. Diff Spores
Pulsed xenon, a form of ultraviolet (UV) light technology, has emerged as a promising tool in the fight against *Clostridioides difficile* (C. diff) spores, which are notoriously resilient and difficult to eradicate. Unlike traditional UV systems, pulsed xenon emits high-intensity, broad-spectrum light in short bursts, targeting a wider range of pathogens. Studies have shown that this technology can effectively inactivate C. diff spores on surfaces, reducing their viability by up to 99.99% after a single treatment cycle. This is particularly significant in healthcare settings, where C. diff infections are a leading cause of hospital-acquired illnesses.
To maximize the effectiveness of pulsed xenon against C. diff spores, proper application is critical. Treatment cycles typically range from 5 to 15 minutes, depending on the device and the surface area being disinfected. For example, a 10-minute exposure at a distance of 1 meter has been shown to achieve substantial spore reduction. However, efficacy can vary based on factors such as surface type, spore concentration, and environmental conditions. It’s essential to follow manufacturer guidelines and ensure even coverage of the target area to avoid shadowing, which can leave spores intact.
Comparatively, pulsed xenon offers advantages over chemical disinfectants, which may not fully penetrate biofilms or require prolonged contact times. While chemicals like bleach are effective against vegetative C. diff cells, they often struggle with spores. Pulsed xenon, on the other hand, disrupts spore DNA and cellular structures through photochemical reactions, rendering them non-viable. This non-chemical approach also reduces the risk of resistance development and minimizes environmental impact, making it a sustainable option for infection control.
Practical implementation of pulsed xenon in healthcare settings requires careful planning. High-risk areas, such as patient rooms and bathrooms, should be prioritized for treatment. Devices should be operated by trained personnel to ensure safety and efficacy, as improper use can lead to suboptimal results. Additionally, combining pulsed xenon with routine cleaning protocols can enhance overall disinfection efforts. For instance, using pulsed xenon after manual cleaning can address residual spores that chemicals may miss, creating a more comprehensive approach to C. diff prevention.
In conclusion, pulsed xenon is a highly effective tool for neutralizing C. diff spores, offering a rapid, non-chemical solution for surface disinfection. Its ability to inactivate spores in a single treatment cycle makes it a valuable addition to infection control strategies, particularly in healthcare environments. By understanding its mechanisms, optimizing application, and integrating it into existing protocols, facilities can significantly reduce the risk of C. diff transmission and improve patient safety.
Tetanus Spores and Ozone Resistance: Uncovering the Truth
You may want to see also

Mechanism of Pulsed Xenon Against Spores
Pulsed xenon, a non-chemical disinfection method, has shown promise in combating *Clostridioides difficile* (C. diff) spores, which are notoriously resistant to traditional cleaning agents. The mechanism hinges on the generation of reactive oxygen species (ROS) and ultraviolet (UV) light emitted during the xenon discharge. These ROS, including hydroxyl radicals and superoxide ions, disrupt the spore’s protein and DNA structures, rendering them non-viable. Unlike continuous UV systems, pulsed xenon delivers high-intensity, broad-spectrum light in short bursts, maximizing spore inactivation without prolonged exposure.
To understand its efficacy, consider the spore’s robust structure: a thick protein coat and a dormant core protected by a cortex layer. Pulsed xenon penetrates this armor by generating UV-C light (200–280 nm), which damages nucleic acids, and UV-A/B light (315–400 nm), which activates photosensitizers in the environment to produce ROS. The combination of physical and chemical damage ensures spores cannot germinate or replicate. Studies indicate a 4–6 log reduction in C. diff spores after 5–10 minutes of exposure, depending on the device’s energy output (typically 10–20 kJ/m²).
Practical application requires careful consideration of dosage and surface proximity. For healthcare settings, devices should be positioned 1–2 meters from surfaces, with treatment cycles repeated 2–3 times to ensure thorough coverage. While effective, pulsed xenon is not a standalone solution; it complements manual cleaning by targeting residual spores. Notably, its non-toxic nature makes it safe for use in occupied rooms, unlike chemical disinfectants, which require evacuation.
Comparatively, pulsed xenon outperforms mercury-based UV systems in terms of safety and speed, as it contains no hazardous materials and operates in minutes rather than hours. However, its effectiveness diminishes in shadowed areas or on highly textured surfaces, necessitating proper room preparation. For optimal results, pair pulsed xenon with hydrogen peroxide wipes or chlorine-based cleaners to address both vegetative cells and spores comprehensively.
In summary, pulsed xenon’s dual-action mechanism—UV light and ROS generation—makes it a potent tool against C. diff spores. Its efficiency, safety, and ease of use position it as a valuable addition to infection control protocols, particularly in high-risk environments like hospitals. By understanding its strengths and limitations, practitioners can deploy it strategically to reduce healthcare-associated infections.
Mitosis or Meiosis: How Are Sporangia Spores Produced?
You may want to see also

Optimal Dosage for Spore Inactivation
Pulsed xenon ultraviolet (PX-UV) technology has emerged as a promising tool for inactivating *Clostridioides difficile* (C. diff) spores, a persistent threat in healthcare settings. Determining the optimal dosage for spore inactivation is critical to ensure efficacy while minimizing operational downtime. Research indicates that the effectiveness of PX-UV depends on factors such as exposure time, distance from the source, and the number of treatment cycles. For instance, studies have shown that a single cycle of PX-UV at a distance of 1.5 meters can achieve a 3-log reduction in C. diff spores, but multiple cycles may be necessary for complete inactivation.
To achieve optimal spore inactivation, a systematic approach to dosage is essential. Start with a baseline treatment of 2 cycles at a distance of 1.5 meters, each lasting approximately 5 minutes. Monitor the environment using spore-specific tests, such as ATP bioluminescence or culture-based assays, to assess residual contamination. If spores persist, increase the number of cycles to 3 or 4, ensuring thorough coverage of all surfaces. For high-risk areas, such as patient rooms or bathrooms, consider reducing the distance to 1 meter to intensify the UV exposure.
Practical considerations play a significant role in determining the optimal dosage. For example, in busy healthcare settings, balancing treatment efficacy with room turnover is crucial. A 3-cycle treatment at 1.5 meters, totaling 15 minutes, strikes a reasonable compromise between spore inactivation and operational efficiency. Additionally, ensure that all surfaces are free of shadows or obstructions, as these can reduce the effectiveness of PX-UV. Regularly calibrate the device and follow manufacturer guidelines to maintain consistent output.
Comparing PX-UV to traditional methods, such as chemical disinfectants or mercury vapor UV systems, highlights its advantages in dosage control. Unlike chemicals, which may require prolonged contact times and pose health risks, PX-UV is a dry, non-toxic method that can be precisely tailored to the environment. Similarly, PX-UV offers a broader spectrum of UV light compared to mercury vapor systems, enhancing its ability to penetrate spore coats. However, it is important to note that PX-UV is not a standalone solution; it should complement, not replace, standard cleaning protocols.
In conclusion, the optimal dosage for spore inactivation using pulsed xenon technology requires a tailored approach based on environmental factors and contamination levels. Starting with 2 cycles at 1.5 meters and adjusting based on testing results ensures both efficacy and practicality. By integrating PX-UV into existing infection control strategies, healthcare facilities can significantly reduce the risk of C. diff transmission while maintaining operational efficiency.
Liquid Cultures vs. Spore Syringes: Which Yields Better Results?
You may want to see also
Explore related products

Comparison with Other Disinfection Methods
Pulsed xenon systems offer a unique approach to disinfection, particularly against *Clostridioides difficile* (C. diff) spores, but how do they stack up against traditional methods? Let's dissect the comparison.
Chemical Disinfectants: Traditional disinfectants like bleach (sodium hypochlorite) are effective against C. diff spores but require prolonged contact times (10 minutes or more) and high concentrations (5,000-10,000 ppm). This can be impractical in healthcare settings due to fumes, material compatibility issues, and the need for thorough rinsing. Pulsed xenon, on the other hand, acts within seconds to minutes, leaving no chemical residue and posing no risk of corrosion or irritation.
Ultraviolet (UV) Light: UV-C light is another non-chemical method, but its effectiveness against C. diff spores is variable. Shadows and surface irregularities can limit its reach, and prolonged exposure is often needed. Pulsed xenon, with its broad-spectrum UV output and intense pulsed delivery, penetrates surfaces more effectively and achieves spore inactivation in shorter treatment times.
Hydrogen Peroxide Vapor (HPV): HPV is highly effective against C. diff spores but requires lengthy treatment cycles (hours) and necessitates room evacuation due to its toxicity. Pulsed xenon offers a faster, safer alternative, allowing for more frequent disinfection cycles without disrupting patient care.
Consider a hospital room turnover scenario. Traditional methods might require hours of downtime for disinfection, while pulsed xenon can potentially turn a room around in under 30 minutes, significantly improving patient flow and bed availability.
While pulsed xenon shows promise, it's crucial to remember that no single method is a silver bullet. A comprehensive disinfection strategy should combine multiple approaches, leveraging the strengths of each to create a robust defense against C. diff and other pathogens.
Understanding Spore Ploidy: Haploid or Diploid in Fungi and Plants
You may want to see also

Clinical Applications in Healthcare Settings
Pulsed xenon ultraviolet (PX-UV) technology has emerged as a promising tool in the fight against *Clostridioides difficile* (C. diff) spores, which are notoriously resilient and contribute to healthcare-associated infections. Clinical applications of PX-UV in healthcare settings focus on its ability to rapidly disinfect surfaces and reduce environmental contamination, a critical factor in breaking the chain of C. diff transmission. Unlike traditional UV systems, PX-UV emits a broad spectrum of UV light, including UV-C, which has been shown to effectively inactivate C. diff spores by damaging their DNA. This section explores how PX-UV can be integrated into clinical workflows to enhance infection prevention strategies.
Implementation Steps for PX-UV in Healthcare Settings
To maximize the efficacy of PX-UV, healthcare facilities should follow a structured approach. First, identify high-risk areas such as patient rooms, bathrooms, and equipment surfaces where C. diff spores are likely to persist. Next, incorporate PX-UV disinfection cycles into terminal cleaning protocols, ensuring all surfaces are visible and unobstructed for optimal light exposure. A typical cycle lasts 10–20 minutes per room, depending on the device and room size. Staff training is essential to ensure proper usage and adherence to safety protocols, such as vacating the room during operation to avoid UV exposure. Combining PX-UV with manual cleaning methods creates a layered approach, significantly reducing the risk of C. diff transmission.
Comparative Analysis: PX-UV vs. Traditional Disinfection Methods
While manual cleaning with sporicidal agents like bleach remains a standard practice, it is labor-intensive and may not consistently eliminate C. diff spores. PX-UV offers a faster, more uniform disinfection process, particularly for hard-to-reach areas. Studies have shown that PX-UV can achieve a log reduction of ≥3 in C. diff spore counts, comparable to or exceeding the efficacy of chemical disinfectants. However, PX-UV is not a replacement for manual cleaning but rather a complementary tool. For instance, in a study published in the *American Journal of Infection Control*, PX-UV reduced C. diff contamination by 99.9% in patient rooms, highlighting its potential to enhance existing protocols.
Practical Tips for Optimal Use
To ensure the successful integration of PX-UV, healthcare facilities should consider several practical tips. First, position the device centrally in the room to maximize light dispersion, ensuring all surfaces receive adequate exposure. Second, maintain regular maintenance of PX-UV devices, including bulb replacement as per manufacturer guidelines, to ensure consistent performance. Third, monitor disinfection outcomes through environmental sampling to validate the technology’s effectiveness. Finally, communicate the benefits of PX-UV to staff and patients to foster trust and compliance. For example, placing signage indicating "Room Disinfected with Advanced UV Technology" can reassure patients of the facility’s commitment to infection prevention.
Cautions and Limitations
While PX-UV is a powerful tool, it is not without limitations. UV light cannot penetrate shadows or opaque surfaces, so thorough manual cleaning remains essential. Additionally, PX-UV is ineffective against pathogens in the air or on highly reflective surfaces. Facilities should also be mindful of the initial investment and operational costs associated with PX-UV devices. Lastly, while PX-UV is safe for use in unoccupied rooms, accidental exposure to UV light can cause skin and eye irritation, necessitating strict adherence to safety protocols. By understanding these limitations, healthcare providers can strategically deploy PX-UV to complement, rather than replace, existing disinfection practices.
Incorporating PX-UV into clinical settings offers a proactive approach to combating C. diff spores, particularly in high-risk environments. By following structured implementation steps, leveraging its comparative advantages, and adhering to practical guidelines, healthcare facilities can significantly reduce the risk of C. diff transmission. While not a standalone solution, PX-UV represents a valuable addition to the infection prevention toolkit, enhancing patient safety and operational efficiency in healthcare settings.
Are Shroom Spore Sellers Legitimate? Uncovering the Truth Behind the Hype
You may want to see also
Frequently asked questions
Yes, pulsed xenon ultraviolet (UV) light has been shown to effectively kill *Clostridioides difficile* (C. diff) spores on surfaces. Studies indicate that it can significantly reduce spore viability, making it a valuable tool in infection control.
Pulsed xenon emits high-intensity, broad-spectrum UV light, including UV-C, which damages the DNA of C. diff spores, preventing them from replicating and causing infection. Its rapid, intense bursts enhance its effectiveness compared to traditional UV systems.
Yes, pulsed xenon is considered a reliable and efficient method for disinfecting surfaces contaminated with C. diff spores in healthcare settings. It complements manual cleaning and reduces the risk of healthcare-associated infections when used correctly.